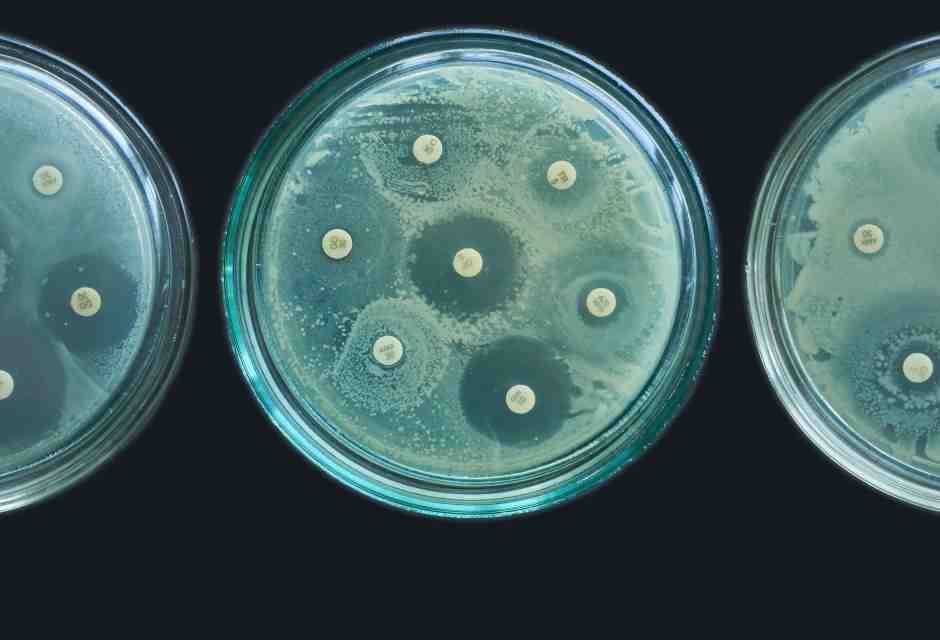
“Contro la farmaco resistenza serve una rivoluzione modello Hiv”. Parla Lucia Aleotti

industria farmaceutica
Economia
Blitz di Trump sui farmaci. L'Ue non si fa trovare impreparata
September 27, 2025
| di Davide Mattone
Economia
Il governo ci riprova con il payback, ma alle pmi di dispositivi medici il compromesso non piace
July 9, 2025
| di Giovanni Rodriquez
Economia
“Contro la farmaco resistenza serve una rivoluzione modello Hiv”. Parla Lucia Aleotti
March 14, 2024
| di Mariarosaria Marchesano
Economia